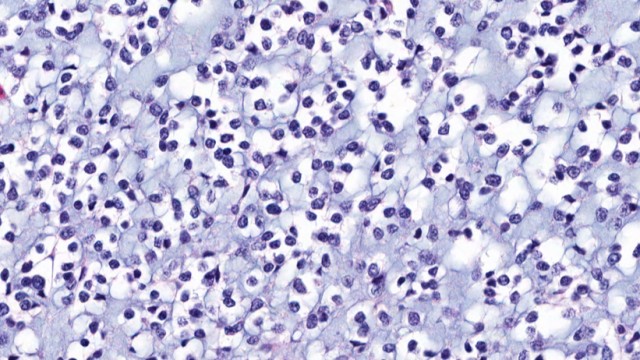

Quote Panel
Key Metrics
Fundamentals
Relative Strength
MTP
Sector
Top 5 RS in Group
Symbol | Company | RS | 5-Day Perf. |
|---|---|---|---|
Forecast
Analyst rating
Last analyst upgrade/downgrade
Chrome Plugin Live! Redefine the way you read FinTwit 🚀 Install Now
Quote Panel
Key Metrics
Fundamentals
Relative Strength
MTP
Sector
Top 5 RS in Group
Symbol | Company | RS | 5-Day Perf. |
|---|---|---|---|
Forecast
Analyst rating
Last analyst upgrade/downgrade
Earnings Growth
YoY
Current
Estimates
Q1.23
N/A
NA
vs NA
Q2.23
N/A
-9.11
vs -150.92
Q3.23
N/A
NA
vs NA
Q4.23
N/A
-41.67
vs -227.76
Q1.24
N/A
NA
vs NA
Q2.24
N/A
-6.38
vs -9.11
Q3.24
N/A
NA
vs NA
Q4.24
N/A
NA
vs -41.67
Q1.25
N/A
NA
vs NA
Q2.25
N/A
NA
vs -6.38
Sales Growth
YoY
Current
Estimates
Q1.23
NA
NA vs NA
Q2.23
-36%
298K vs 468K
Q3.23
NA
NA vs NA
Q4.23
-64%
83K vs 231K
Q1.24
NA
NA vs NA
Q2.24
-100%
NA vs 298K
Q3.24
NA
NA vs NA
Q4.24
-100%
NA vs 83K
Q1.25
NA
NA vs NA
Q2.25
NA
NA vs NA
Return on Equity
QoQ
Q1.23
NA
NA
vs NA
Q2.23
-67%
-0.67
vs -1.45
Q3.23
NA
NA
vs NA
Q4.23
-75%
-0.75
vs -0.67
Q1.24
NA
NA
vs NA
Q2.24
-38%
-0.38
vs -0.75
Q3.24
NA
NA
vs NA
Q4.24
-29%
-0.29
vs -0.38
Q1.25
NA
NA
vs NA
Q2.25
-33%
-0.33
vs -0.29
Institutionnal Ownership
QoQ
Q4.16
4
4
vs 5
-20%
Q1.17
4
4
vs 4
NA
Q2.17
2
2
vs 4
-50%
Q3.17
4
4
vs 2
100%
Q4.17
3
3
vs 4
-25%
Q1.18
4
4
vs 3
33%
Q2.18
6
6
vs 4
50%
Q3.18
5
5
vs 6
-17%
Q4.18
12
12
vs 5
140%
Q1.19
4
4
vs 12
-67%

accesswire.com
2 hours ago
proactiveinvestors.co.uk
4 hours ago

proactiveinvestors.co.uk
7 hours ago

investorplace.com
8 hours ago


seekingalpha.com
15 hours ago
Relative Strength
MTP
Sector
Top 5 RS in Group
Symbol | Company | RS | 5-Day Perf. |
|---|---|---|---|
Quote Panel
Key Metrics
Forecast
2025-Revenue
2025-EPS
2025-EBITDA
Analyst rating
Price Target
N/A(N/A)
Number of analyst
N/A
Last analyst upgrade/downgrade
No Data Available